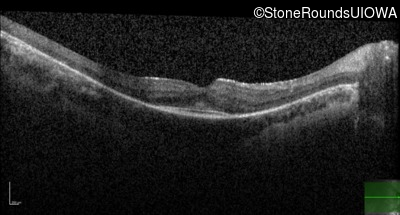
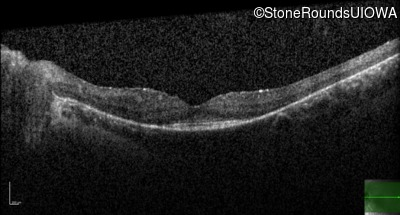

Case
SR132
Student Mode
AR Retinitis Pigmentosa (IA1aiii)
Male
Male
Hidden
SR132
Student Mode
AR Retinitis Pigmentosa (IA1aiii)
Male
Male
History
This 22 year old man noticed some difficulty driving at night during the past year.
| Age at visit: 22 years |
| Age at visit: 26 years |
| OD | OS | ||
|---|---|---|---|
Diagnosis & molecular findings
| Disease | Gene | Allele 1 variant(s) | Allele 2 variant(s) | Inheritance mode |
|---|---|---|---|---|
| AR Retinitis Pigmentosa | CLN3 | Deletion Exons 9-10 | Arg405Trp CGG>TGG | AR |
Disease:
Gene:
Allele 1:
Deletion Exons 9-10
Allele 2:
Arg405Trp CGG>TGG
Inheritance:
AR